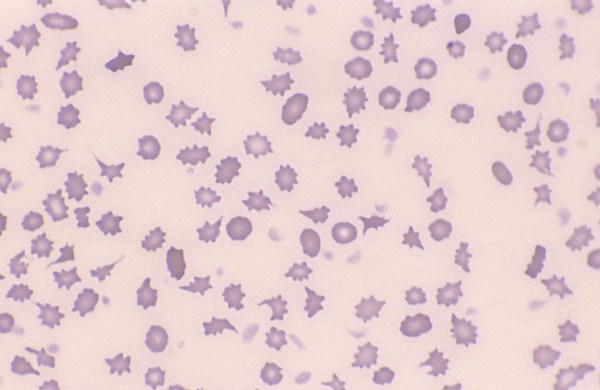
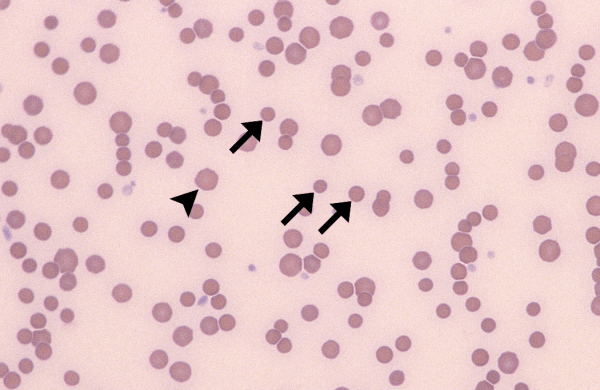
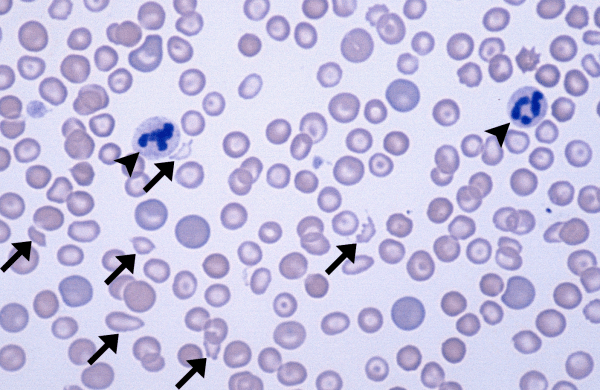
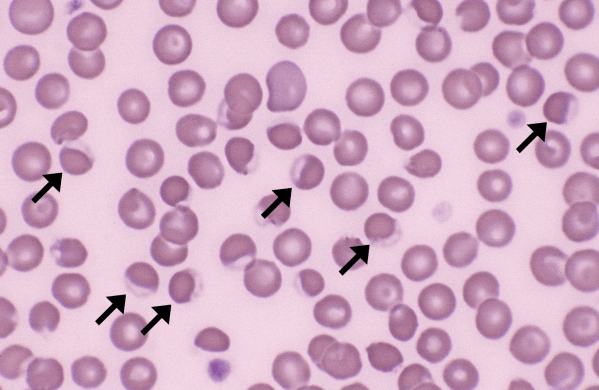
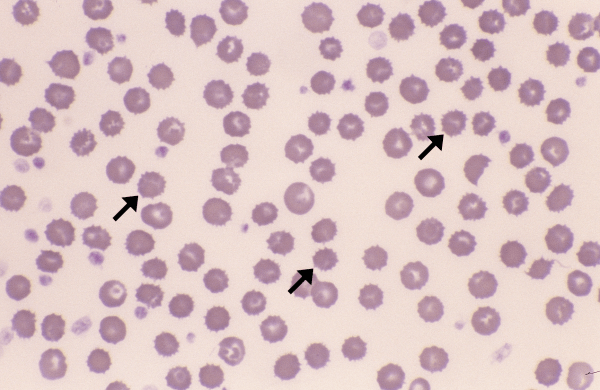

Morphology: poikilocyte is a generic term to describe red blood cells with abnormal shape. Poikilocytosis refers to large numbers of abnormally shaped red blood cells. Commonly seen with: poikilocytosis may include… Read more Poikilocytosis →

Morphology: red blood cells with a spherical rather than biconcave shape. Spherocytes appear smaller than normal red blood cells, with loss of central pallor in dogs. Look alike: microcytes (may be… Read more Spherocytes →

Also called: blister cells (vesicle), helmet cells (ruptured) Morphology: red blood cells with a blister-like vesicle on the margin, or a bite-shaped defect with horn-like projections on the margin (which results… Read more Keratocytes →

Also called: schistocytes Morphology: red blood cell fragments. Usually oblong with irregular margins, but may appear in a variety of shapes and sizes. Commonly seen with: keratocytes and acanthocytes (if caused by… Read more Schizocytes →

Morphology: red blood cells with a clear crescent-shaped area along one side of the periphery. Formed by the fusion of two layers of oxidized cell membrane with no hemoglobin in between.… Read more Eccentrocytes →

Morphology: red blood cells with small, regular spicules projecting from the cell surface. Spicules are uniform in shape with sharp or blunt tips, uniform in length, and evenly spaced around the… Read more Echinocytes →

Morphology: red blood cells with irregular spicules projecting from the cell surface. Spicules are variable in shape (blunt or bulbous tips), variable in size, and unevenly distributed around the periphery of… Read more Acanthocytes →